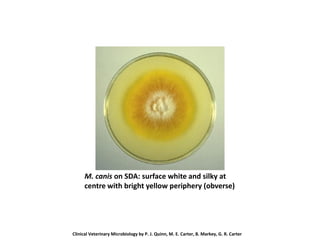
M. canis on SDA: surface white and silky at
centre with bright yellow periphery (obverse)
Clinical Veterinary Microbiology by P. J. Quinn, M. E. Carter, B. Markey, G. R. Carter
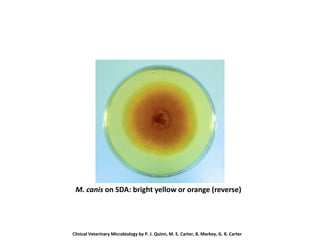
M. canis on SDA: bright yellow or orange (reverse)
Clinical Veterinary Microbiology by P. J. Quinn, M. E. Carter, B. Markey, G. R. Carter
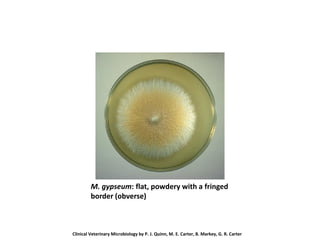
M. gypseum: flat, powdery with a fringed
border (obverse)
Clinical Veterinary Microbiology by P. J. Quinn, M. E. Carter, B. Markey, G. R. Carter
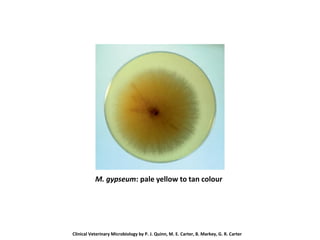
M. gypseum: pale yellow to tan colour
Clinical Veterinary Microbiology by P. J. Quinn, M. E. Carter, B. Markey, G. R. Carter
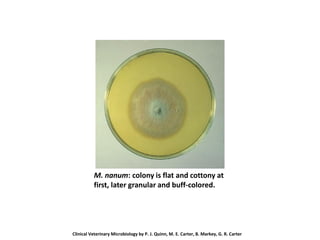
M. nanum: colony is flat and cottony at
first, later granular and buff-colored.
Clinical Veterinary Microbiology by P. J. Quinn, M. E. Carter, B. Markey, G. R. Carter
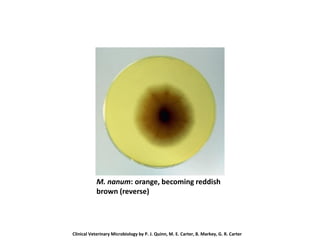
M. nanum: orange, becoming reddish
brown (reverse)
Clinical Veterinary Microbiology by P. J. Quinn, M. E. Carter, B. Markey, G. R. Carter
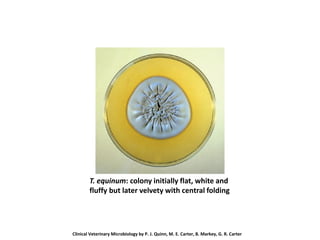
T. equinum: colony initially flat, white and
fluffy but later velvety with central folding
Clinical Veterinary Microbiology by P. J. Quinn, M. E. Carter, B. Markey, G. R. Carter
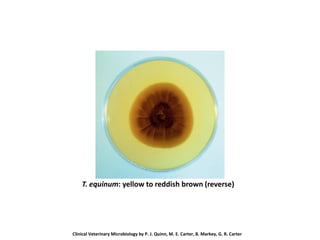
T. equinum: yellow to reddish brown (reverse)
Clinical Veterinary Microbiology by P. J. Quinn, M. E. Carter, B. Markey, G. R. Carter
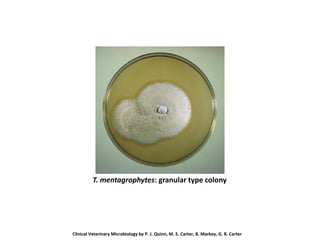
T. mentagrophytes: granular type colony
Clinical Veterinary Microbiology by P. J. Quinn, M. E. Carter, B. Markey, G. R. Carter
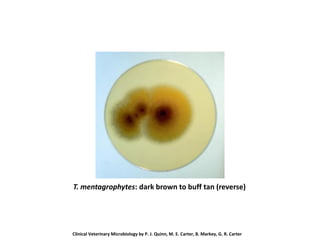
T. mentagrophytes: dark brown to buff tan (reverse)
Clinical Veterinary Microbiology by P. J. Quinn, M. E. Carter, B. Markey, G. R. Carter

Dermatophytes are fungi that can infect the skin, hair, and nails of humans and animals. There are three main genera: Microsporum, Trichophyton, and Epidermophyton. They grow slowly in culture and produce macroconidia or arthrospores. Microsporum species commonly cause ringworm infections in various animal hosts like horses, cattle, pigs, and chickens. Trichophyton species are also important animal pathogens and can infect multiple host species. Laboratory identification involves examining fungal culture morphology and microscopic characteristics of spores. Dermatophytes are an important cause of ringworm infections in veterinary medicine.